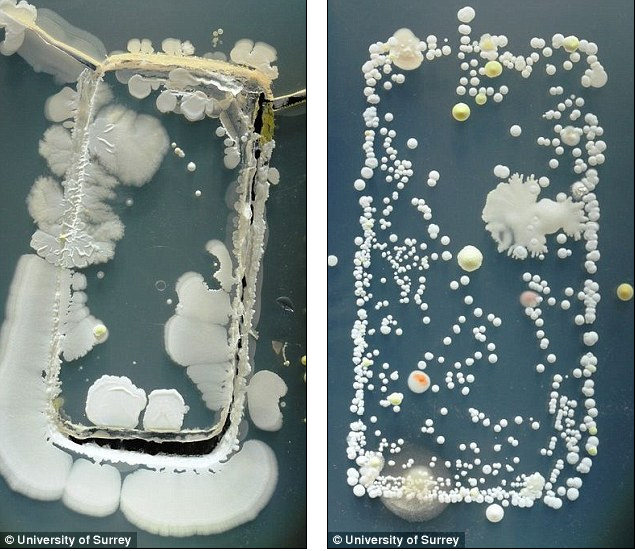
Những vi khuẩn có trong điện thoại

Ngày nay điện thoại là một vật bất ly thân không thể thiếu đối với mỗi chúng ta, điện thoại giúp chúng ta liên lạc và trao đổi công việc một cách dễ dàng hơn. Tuy nhiên bạn có biết chiếc điện thoại, vật bất ly thân đó lại là nơi chứa vi khuẩn cao hơn gấp 10 lần so với vi khuẩn trong nhà vệ sinh không?
Theo các nghiên cứu cho rằng, hầu hết người sử dụng điện thoại rất ít khi vệ sinh điện thoại. Trong một thí nghiệm với 192 chiếc điện thoại di động, người ta đã phát hiện có 91,7% số điện thoại bị nhiễm khuẩn và cứ 6 chiếc thì có 1 chiếc bị nhiễm các vi khuẩn có trong phân. Hầu hết các loại vi khuẩn này bắt nguồn từ ngón tay của bạn khi sử dụng điện thoại. Nếu bạn không tin thì những hình ảnh dưới đây sẽ chứng minh cho bạn thấy chiếc điện thoại của bạn bẩn như thế nào, và làm sao để vệ sinh nó đúng cách.
1. Điện thoại của bạn bẩn đến mức nào?

2. Cách làm sạch điện thoại của bạn

3. Cách làm sạch tai nghe

Học IT










Công nghệ
Microsoft Word 2013
Microsoft Word 2007
Microsoft Excel 2019
Microsoft Excel 2016
Microsoft PowerPoint 2019
Google Sheets
Lập trình Scratch
Bootstrap
Hướng dẫn
Ô tô, Xe máy